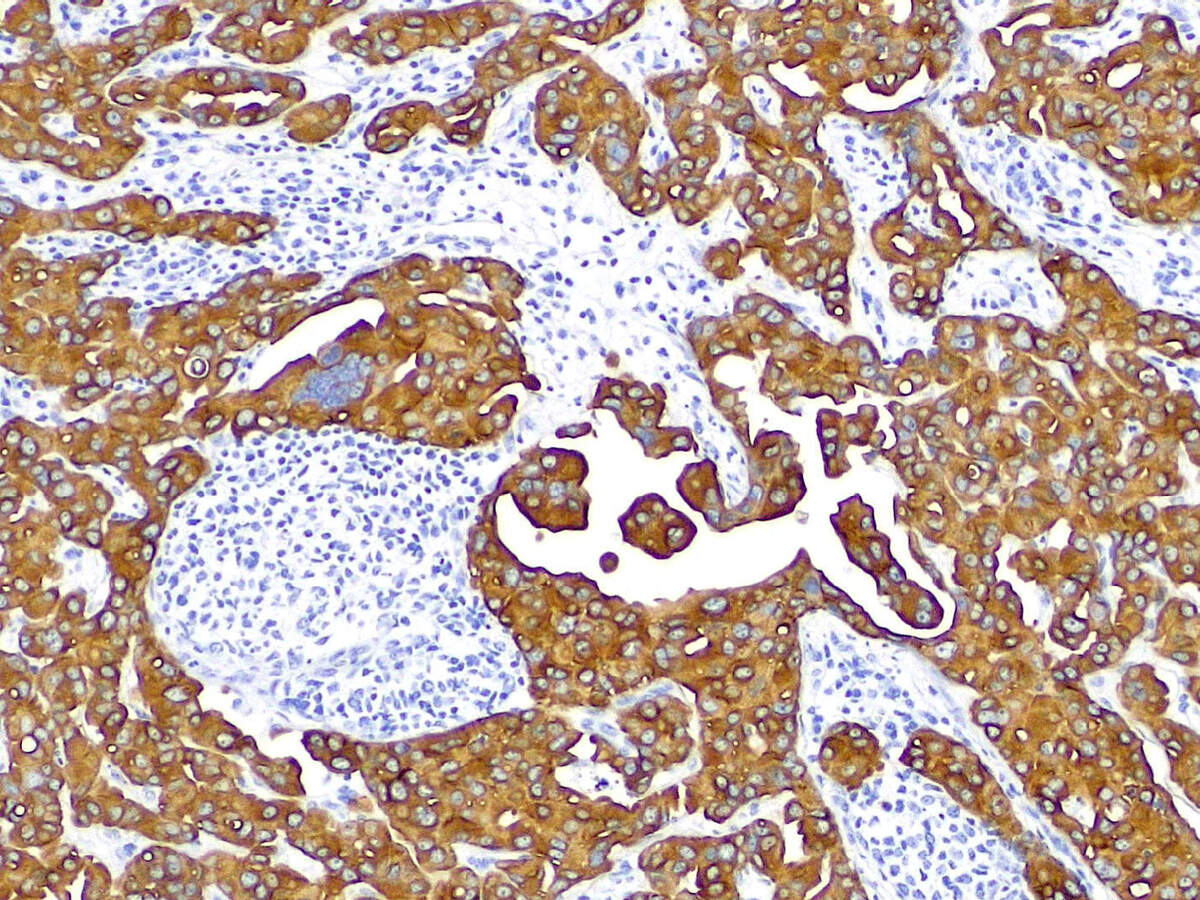

【基础知识】光学显微镜的基本观察方式——明场观察
明场观察(Bright field),是显微镜技术中最基础且应用广泛的观察手段之一。这种方法利用均匀分布的光线直接照射在样本上,使观察者能够清晰地看到样本中吸收或散射光线的部分,从而获取其形貌和结构信息。

明场观察的原理相对直接,无需复杂的附件或设备。仅需将样本妥善放置在载物台上,通过显微镜的物镜和目镜进行细致的观察和放大。由于光线直接且均匀地投射在样本上,视野呈现出高亮度且均匀的照明效果,使样本的细节和特征得以清晰展现。
明场观察方式在多个学科领域都发挥着不可或缺的作用。在生物学领域,它常被用于研究细胞、组织、细菌等生物样本的微观结构和功能。在医学领域,明场观察则是病理学检查、临床实验室检测和血液分析等工作的重要辅助手段,为医生提供了宝贵的诊断依据。此外,在材料科学、环境科学等领域,明场观察同样发挥着重要作用,有助于研究人员深入了解材料的微观结构和性质。
然而,明场观察方式也存在一些局限性。例如,对于透明样本,由于光线能够轻易穿透,导致对比度较低,使得样本的细节难以呈现。此外,由于物镜的工作距离有限,对于较厚的样本往往无法直接进行观察。为了克服这些限制,研究者们通常会采用其他观察方式,如暗场观察、偏光观察等,以获取更为全面和准确的样本信息。
综上所述,对于明场观察其
优点:
应用广泛,操作简单;
视野亮度高、均匀;
较好的色彩还原、图像平坦;
价格相对较低。
缺点:成像对比度低(透明或未染色标本)、缺乏立体感、应用局限。
应用领域:常规镜检、病理、染色标本

信息咨询:
如果无法找到您需要的产品或信息,请与我们联系 order@mayduly.com.

